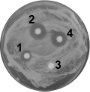

Synthesis in the glycosciences II

Christian-Albrechts-Universität zu Kiel
See also the Thematic Series:
Synthesis in the glycosciences
Multivalent glycosystems for nanoscience
See videos about glycoscience at Beilstein TV.
Synthesis in the glycosciences II
- Thisbe K. Lindhorst
Beilstein J. Org. Chem. 2012, 8, 411–412, doi:10.3762/bjoc.8.45

Acceptor-influenced and donor-tuned base-promoted glycosylation
- Stephan Boettcher,
- Martin Matwiejuk and
- Joachim Thiem
Beilstein J. Org. Chem. 2012, 8, 413–420, doi:10.3762/bjoc.8.46
Synthesis of heteroglycoclusters by using orthogonal chemoselective ligations
- Baptiste Thomas,
- Michele Fiore,
- Isabelle Bossu,
- Pascal Dumy and
- Olivier Renaudet
Beilstein J. Org. Chem. 2012, 8, 421–427, doi:10.3762/bjoc.8.47
Facile synthesis of nitrophenyl 2-acetamido-2-deoxy-α-D-mannopyranosides from ManNAc-oxazoline
- Karel Křenek,
- Petr Šimon,
- Lenka Weignerová,
- Barbora Fliedrová,
- Marek Kuzma and
- Vladimír Křen
Beilstein J. Org. Chem. 2012, 8, 428–432, doi:10.3762/bjoc.8.48
Synthesis of fluorinated maltose derivatives for monitoring protein interaction by 19F NMR
- Michaela Braitsch,
- Hanspeter Kählig,
- Georg Kontaxis,
- Michael Fischer,
- Toshinari Kawada,
- Robert Konrat and
- Walther Schmid
Beilstein J. Org. Chem. 2012, 8, 448–455, doi:10.3762/bjoc.8.51
Electrochemical generation of 2,3-oxazolidinone glycosyl triflates as an intermediate for stereoselective glycosylation
- Toshiki Nokami,
- Akito Shibuya,
- Yoshihiro Saigusa,
- Shino Manabe,
- Yukishige Ito and
- Jun-ichi Yoshida
Beilstein J. Org. Chem. 2012, 8, 456–460, doi:10.3762/bjoc.8.52
Synthesis and biological evaluation of nojirimycin- and pyrrolidine-based trehalase inhibitors
- Davide Bini,
- Francesca Cardona,
- Matilde Forcella,
- Camilla Parmeggiani,
- Paolo Parenti,
- Francesco Nicotra and
- Laura Cipolla
Beilstein J. Org. Chem. 2012, 8, 514–521, doi:10.3762/bjoc.8.58
Branching out at C-2 of septanosides. Synthesis of 2-deoxy-2-C-alkyl/aryl septanosides from a bromo-oxepine
- Supriya Dey and
- Narayanaswamy Jayaraman
Beilstein J. Org. Chem. 2012, 8, 522–527, doi:10.3762/bjoc.8.59
Cyanoethylation of the glucans dextran and pullulan: Substitution pattern and formation of nanostructures and entrapment of magnetic nanoparticles
- Kathrin Fiege,
- Heinrich Lünsdorf,
- Sevil Atarijabarzadeh and
- Petra Mischnick
Beilstein J. Org. Chem. 2012, 8, 551–566, doi:10.3762/bjoc.8.63
2-Allylphenyl glycosides as complementary building blocks for oligosaccharide and glycoconjugate synthesis
- Hemali D. Premathilake and
- Alexei V. Demchenko
Beilstein J. Org. Chem. 2012, 8, 597–605, doi:10.3762/bjoc.8.66
An easy α-glycosylation methodology for the synthesis and stereochemistry of mycoplasma α-glycolipid antigens
- Yoshihiro Nishida,
- Yuko Shingu,
- Yuan Mengfei,
- Kazuo Fukuda,
- Hirofumi Dohi,
- Sachie Matsuda and
- Kazuhiro Matsuda
Beilstein J. Org. Chem. 2012, 8, 629–639, doi:10.3762/bjoc.8.70
Carbohydrate-auxiliary assisted preparation of enantiopure 1,2-oxazine derivatives and aminopolyols
- Marcin Jasiński,
- Dieter Lentz and
- Hans-Ulrich Reissig
Beilstein J. Org. Chem. 2012, 8, 662–674, doi:10.3762/bjoc.8.74
Sonogashira–Hagihara reactions of halogenated glycals
- Dennis C. Koester and
- Daniel B. Werz
Beilstein J. Org. Chem. 2012, 8, 675–682, doi:10.3762/bjoc.8.75
Synthesis and antiviral activities of spacer-linked 1-thioglucuronide analogues of glycyrrhizin
- Christian Stanetty,
- Andrea Wolkerstorfer,
- Hassan Amer,
- Andreas Hofinger,
- Ulrich Jordis,
- Dirk Claßen-Houben and
- Paul Kosma
Beilstein J. Org. Chem. 2012, 8, 705–711, doi:10.3762/bjoc.8.79
Chemo-enzymatic modification of poly-N-acetyllactosamine (LacNAc) oligomers and N,N-diacetyllactosamine (LacDiNAc) based on galactose oxidase treatment
- Christiane E. Kupper,
- Ruben R. Rosencrantz,
- Birgit Henßen,
- Helena Pelantová,
- Stephan Thönes,
- Anna Drozdová,
- Vladimir Křen and
- Lothar Elling
Beilstein J. Org. Chem. 2012, 8, 712–725, doi:10.3762/bjoc.8.80
Synthesis and antifungal properties of papulacandin derivatives
- Marjolein van der Kaaden,
- Eefjan Breukink and
- Roland J. Pieters
Beilstein J. Org. Chem. 2012, 8, 732–737, doi:10.3762/bjoc.8.82
Formation of carbohydrate-functionalised polystyrene and glass slides and their analysis by MALDI-TOF MS
- Martin J. Weissenborn,
- Johannes W. Wehner,
- Christopher J. Gray,
- Robert Šardzík,
- Claire E. Eyers,
- Thisbe K. Lindhorst and
- Sabine L. Flitsch
Beilstein J. Org. Chem. 2012, 8, 753–762, doi:10.3762/bjoc.8.86
Triterpenoid saponins from the roots of Acanthophyllum gypsophiloides Regel
- Elena A. Khatuntseva,
- Vladimir M. Men’shov,
- Alexander S. Shashkov,
- Yury E. Tsvetkov,
- Rodion N. Stepanenko,
- Raymonda Ya. Vlasenko,
- Elvira E. Shults,
- Genrikh A. Tolstikov,
- Tatjana G. Tolstikova,
- Dimitri S. Baev,
- Vasiliy A. Kaledin,
- Nelli A. Popova,
- Valeriy P. Nikolin,
- Pavel P. Laktionov,
- Anna V. Cherepanova,
- Tatiana V. Kulakovskaya,
- Ekaterina V. Kulakovskaya and
- Nikolay E. Nifantiev
Beilstein J. Org. Chem. 2012, 8, 763–775, doi:10.3762/bjoc.8.87
An easily accessible sulfated saccharide mimetic inhibits in vitro human tumor cell adhesion and angiogenesis of vascular endothelial cells
- Grazia Marano,
- Claas Gronewold,
- Martin Frank,
- Anette Merling,
- Christian Kliem,
- Sandra Sauer,
- Manfred Wiessler,
- Eva Frei and
- Reinhard Schwartz-Albiez
Beilstein J. Org. Chem. 2012, 8, 787–803, doi:10.3762/bjoc.8.89
Synthetic glycopeptides and glycoproteins with applications in biological research
- Ulrika Westerlind
Beilstein J. Org. Chem. 2012, 8, 804–818, doi:10.3762/bjoc.8.90
High-affinity multivalent wheat germ agglutinin ligands by one-pot click reaction
- Henning S. G. Beckmann,
- Heiko M. Möller and
- Valentin Wittmann
Beilstein J. Org. Chem. 2012, 8, 819–826, doi:10.3762/bjoc.8.91
The use of glycoinformatics in glycochemistry
- Thomas Lütteke
Beilstein J. Org. Chem. 2012, 8, 915–929, doi:10.3762/bjoc.8.104

Low-generation dendrimers with a calixarene core and based on a chiral C2-symmetric pyrrolidine as iminosugar mimics
- Marco Marradi,
- Stefano Cicchi,
- Francesco Sansone,
- Alessandro Casnati and
- Andrea Goti
Beilstein J. Org. Chem. 2012, 8, 951–957, doi:10.3762/bjoc.8.107
Synthesis and structure of tricarbonyl(η6-arene)chromium complexes of phenyl and benzyl D-glycopyranosides
- Thomas Ziegler and
- Ulrich Heber
Beilstein J. Org. Chem. 2012, 8, 1059–1070, doi:10.3762/bjoc.8.118
Synthesis of 4” manipulated Lewis X trisaccharide analogues
- Christopher J. Moore and
- France-Isabelle Auzanneau
Beilstein J. Org. Chem. 2012, 8, 1134–1143, doi:10.3762/bjoc.8.126
Studies on the substrate specificity of a GDP-mannose pyrophosphorylase from Salmonella enterica
- Lu Zou,
- Ruixiang Blake Zheng and
- Todd L. Lowary
Beilstein J. Org. Chem. 2012, 8, 1219–1226, doi:10.3762/bjoc.8.136
Automated synthesis of sialylated oligosaccharides
- Davide Esposito,
- Mattan Hurevich,
- Bastien Castagner,
- Cheng-Chung Wang and
- Peter H. Seeberger
Beilstein J. Org. Chem. 2012, 8, 1601–1609, doi:10.3762/bjoc.8.183
The Amadori rearrangement as glycoconjugation method: Synthesis of non-natural C-glycosyl type glycoconjugates
- Katharina Gallas,
- Gerit Pototschnig,
- Florian Adanitsch,
- Arnold E. Stütz and
- Tanja M. Wrodnigg
Beilstein J. Org. Chem. 2012, 8, 1619–1629, doi:10.3762/bjoc.8.185
A new approach toward the total synthesis of (+)-batzellaside B
- Jolanta Wierzejska,
- Shin-ichi Motogoe,
- Yuto Makino,
- Tetsuya Sengoku,
- Masaki Takahashi and
- Hidemi Yoda
Beilstein J. Org. Chem. 2012, 8, 1831–1838, doi:10.3762/bjoc.8.210
Acylsulfonamide safety-catch linker: promise and limitations for solid–phase oligosaccharide synthesis
- Jian Yin,
- Steffen Eller,
- Mayeul Collot and
- Peter H. Seeberger
Beilstein J. Org. Chem. 2012, 8, 2067–2071, doi:10.3762/bjoc.8.232
S-Fluorenylmethyl protection of the cysteine side chain upon Nα-Fmoc deprotection
- Johannes W. Wehner and
- Thisbe K. Lindhorst
Beilstein J. Org. Chem. 2012, 8, 2149–2155, doi:10.3762/bjoc.8.242
Peptoids and polyamines going sweet: Modular synthesis of glycosylated peptoids and polyamines using click chemistry
- Daniel Fürniss,
- Timo Mack,
- Frank Hahn,
- Sidonie B. L. Vollrath,
- Katarzyna Koroniak,
- Ute Schepers and
- Stefan Bräse
Beilstein J. Org. Chem. 2013, 9, 56–63, doi:10.3762/bjoc.9.7
Glycosylation efficiencies on different solid supports using a hydrogenolysis-labile linker
- Mayeul Collot,
- Steffen Eller,
- Markus Weishaupt and
- Peter H. Seeberger
Beilstein J. Org. Chem. 2013, 9, 97–105, doi:10.3762/bjoc.9.13
De novo synthesis of D- and L-fucosamine containing disaccharides
- Daniele Leonori and
- Peter H. Seeberger
Beilstein J. Org. Chem. 2013, 9, 332–341, doi:10.3762/bjoc.9.38